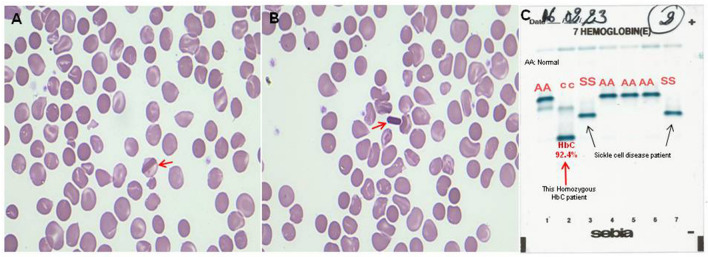
Fig. 1

Abstract
The typical rod-shaped HbC crystals in the peripheral blood smear often provide the diagnostic clue to the HbC disease. This case highlights that a careful review of blood film morphology may be helpful to detect HbC disease, although this case's routine blood test is normal and do not meet the rules of re-examinations.
Keywords: Rod-shaped hemoglobin crystals, Clues, Hemoglobin C disease
A 25 years-old West African woman presented with episodic generalized body ache for two months. The pain was initially present in the back and both arms. The painful episodes lasted for 2–3 days and were relieved after using tramadol. General and systemic physical examinations were normal. At admission, hematological investigations showed hemoglobin 130 g/L, total leukocyte count 5.9 × 109/L and platelets 304 × 109/L. RBC indices were normal. Biochemical investigations were within normal limits. A careful review of the peripheral blood smear showed features of homozygous hemoglobin C (HbC) disease: anisopolikilocytosis and rod-shaped HbC crystals (Fig. 1A, B, red arrow). Only occasional target cells were seen. Hemoglobin electrophoresis showed HbF-4.2%, HbA2-3.4%, and HbC-92.4% (red arrow, Fig. 1C). Testing of the patient’s two sons and one daughter showed heterozygosity for HbC.
Fig. 1.
Peripheral blood smear of West African 25-year-old woman presenting with systemic pain. A, B Anisocytosis, poikilocytosis, and rod-shaped HbC crystals (red arrow) were observed on the blood smear. C The haemoglobin electrophoresis showed HbF 4.2%, HbA2 3.4%, and HbC 92.4% (red arrow) in this homozygous HbC patient, and other two sickle cell disease patients (black arrow)
Homozygous HbC disease is generally a benign condition associated with splenomegaly and hemolytic anaemia [1]. Our patient presented with systemic pain, possibly due to vaso-occlusive crisis with no precipitating factor. The typical rod-shaped HbC crystals in the peripheral blood smear often provide the initial diagnostic clue to the presence of HbC disease [2]. This case emphasizes that a careful review of blood film morphology may be helpful to detect HbC disease.
Author Contribution
KX, BsID, YLD provide the picture and clinical data. JZ and YZ analyzed the data and provide support. JL designed, analyzed the data and wrote the manuscript.
Declarations
Conflict of interest
The authors declare that they have no conflict of interest.
Ethical Approval
This patient signed to publish this paper.
Informed Consent
All authors reviewed this manuscript and agreed to submit this manuscript.
Footnotes
Publisher's Note
Springer Nature remains neutral with regard to jurisdictional claims in published maps and institutional affiliations.
References
- 1.Fairhurst RM, Casella JF. Images in clinical medicine. Homozygous hemoglobin C disease. N Engl J Med. 2004;350:e24. doi: 10.1056/NEJMicm030486. [DOI] [PubMed] [Google Scholar]
- 2.Dalia S, Zhang L. Homozygous hemoglobin C disease. Blood. 2013;122:1694. doi: 10.1182/blood-2013-04-498188. [DOI] [PubMed] [Google Scholar]